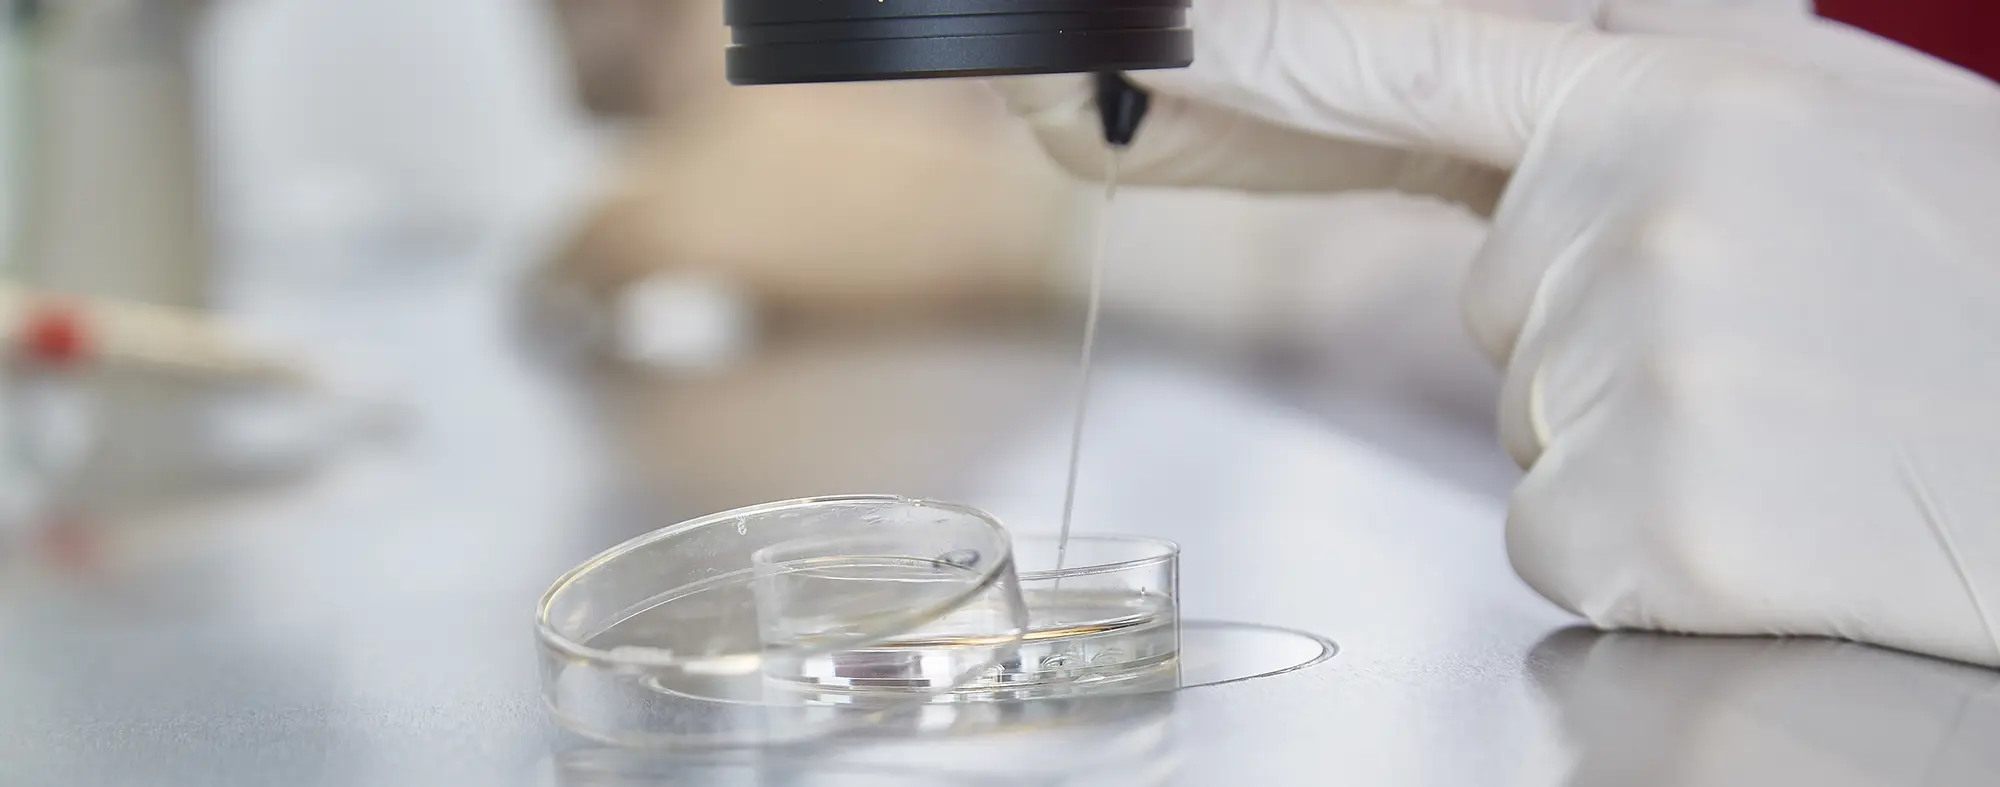

Fertility-preserving measures - Fertility doctors Berlin
A woman's or man's fertility is not a given for a lifetime. Age, illness, medical treatment and genetic factors can have a significant impact on fertility. Modern cancer therapies in particular, such as chemotherapy or radiotherapy, as well as chronic illnesses or surgery on the reproductive organs, can permanently restrict the ability to have children later on. Fertility-preserving measures - also known as fertility protection - offer the possibility of preserving one's own chances of becoming pregnant at a later date. These measures are not only intended for patients with a medical need, but also for women and men who wish to consciously postpone their family planning to the future.
Methods for women
Women have several options for preserving their fertility. One of the best-known methods is the freezing of unfertilised eggs (social freezing). The eggs are retrieved, frozen in the laboratory by vitrification and later used for artificial fertilisation. Women with a partner also have the option of having fertilised eggs (embryos) frozen at the pronuclear stage. According to the Embryo Protection Act in Germany, this means that although the genetic material of the sperm is already in the egg cell, it has not yet fused with the genetic material of the egg cell to form a cell nucleus.
Ovarian tissue freezing is an alternative option for patients whose ovaries could be damaged by medical therapy. This involves surgically removing a small portion of the ovarian tissue, freezing it and reinserting it at a later date. This technique can restore natural hormonal function and the possibility of pregnancy, even if ovarian function has been lost due to treatment.
Fertility preservation is not only a medical decision, but also an emotional one. The choice of the right measure is always individualised and should be made in close consultation with experienced reproductive physicians. Thanks to modern techniques such as vitrification and cryopreservation, the chances of success are higher today than ever before. At our fertility clinic in Berlin, we can work with you to develop an optimal strategy for preserving your fertility based on your health history, age and life plan. Please contact us for further information and advice.
Make an appointment now